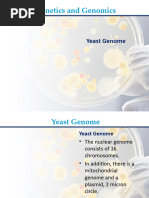

LABORATORY SERVICES
Patient Name Mozammel Haque
Lab No 70608052
UHID 70408424
Sample Date *706
13/05/2024 10:09AM
Age/Gender 64 Yrs/Male 13/05/2024 11:53AM
Receiving Date
Referred By Prof. Dr. Syed Rezaul Huq, MBBS(DMC). MD Report Date 13/05/2024 3:19PM
(Chest Medicine). MCPS(Medicine). DTCD Report Status Final
(Chest). FCCP(USA). BCS(Health).
Test Name Result Unit Reference Range
HAEMATOLOGY
CBC, ESR Sample: WHOLE BLOOD
Total Count
White Blood Cells 11.04 K / µL 4.00 - 10.00
Neutrophils 8.61 K / µL 2.00 - 7.00
Lymphocyte 1.66 K / µL 1.00 - 3.00
Monocyte 0.66 K / µL 0.20 - 1.00
Eosinophil 0.11 K / µL 0.02 - 0.50
Differential Leucocyte Count
Neutrophil% 78 % 40.00 - 80.00
Lymphocyte% 15 % 20.00 - 40.00
Monocyte% 6 % 2.00 - 10.00
Eosinophil% 1 % 1.00 - 6.00
Basophil% 0 % <1-2
Red Blood Cells 4.81 million/µl 4.50 - 5.50
Haemoglobin 12.10 g/dL 13.00 - 17.00
HCT 38.50 % 38.90 - 50.90
MCV 80.0 fl 81 - 94
MCH 25.2 pg 27 - 33
MCHC 31.4 g/dL 33 - 37
RDW-CV(%) 14.8 % 12 - 14
Platelets 150 K / µL 150 - 410
ESR 27 mm/hr 0 - 14
ASST. PROF. ZINAT REHENA
MBBS, BCS (Health), M.Phill (Clinical Pathology)
S.S.M.C & Mitford Hospital
Consultant Pathologist
Prepared By: MD RAKIBUL ISLAM Printed By: Printed at 13/05/2024 22:14 Page: 1 Of 1